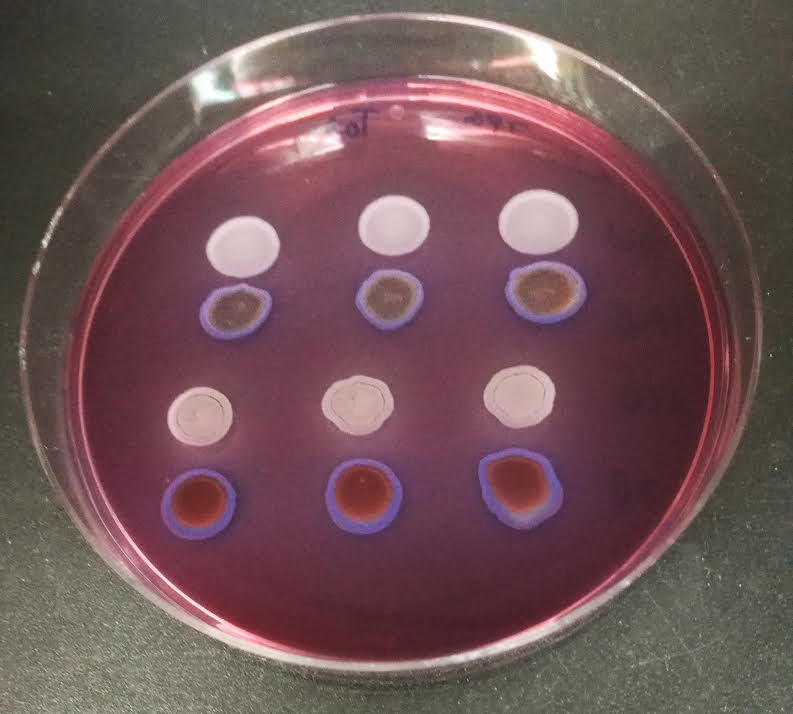
UniversidadAnd's tweet image. 🔬Investigadores andaluces demuestran los beneficios de una comunidad bacteriana contra el cambio climático en el tomate

🍅 La herramienta protege a la planta contra el calor, tiene financiación de @UniversidadAnd y se pone a disposición del agricultor ➡️ lajunta.es/571c9

Kratoscience
@kratoscience
Cordobesista, madridista y loco por la ciencia 🧪 ⚽️
Was dir gefallen könnte
👽👽👽👽👽😱🤯
🗣️IV Workshop on Materials for Photocatalysis, Energy and Clean Environment (IV WMPECE) uco.es/centros/invest… #WMPECE26

New publication under DurInnPack PRIMA project with the collaboration of several project partners! @Fac_CienciasUCO @IQUEMA_ @CSIC link.springer.com/article/10.100… 🍅🧪
These days @dur_pack project was represented by our science coordinator @AraGarNu from @Fac_CienciasUCO and our partner Cecilia Conti from @LaStatale at Project Day 2025 hosted by @PrimaProgram in Barcelona 🍅🥒📦🧪




Teniamos que encontrar cuatro peores que el @CordobaCF_ofi , pues ya hemos encontrado uno el Real Zaragoza … quedan 3
Otra vez mdpi en la picota. Sin embargo, muchos investigadores están felices de publicar en revistas con procesos de revisión cuestionables como las de este grupo editorial. Qué fácil es mirar para otro lado. deevybee.blogspot.com/2025/07/troubl…
🗣️¡Reserva la fecha! El II Congreso de Química Aplicada a la Energía y al Medio Ambiente – #QUIEMA2025 se celebrará los días 3 y 4 de septiembre de 2025 en Córdoba. Organiza: Instituto Químico para la Energía y el Medioambiente @IQUEMA_ Inscripciones congresoquiema.es

🗣️ Comenzamos el día compartiendo la entrevista del Diario @cordoba a nuestro Director Luis Sánchez @LSanGran 🔝 El @IQUEMA_ @Univcordoba persigue ser un referente internacional en #energíarenovable #biocombustibles #biomateriales #química #medioambiente diariocordoba.com/universidad/20…
🔄 Baterías sostenibles a partir del alpeorujo 🫒 El proyecto Olive4Future de la @Univcordoba busca transformar este producto, que se genera durante la extracción del aceite de oliva, para evitar la generación de residuos industriales. 📺 @RTVEAndalucia
🌱 DURINNPACK: THE REVOLUTION OF SUSTAINABLE PACKAGING FOR POST-HARVEST FRUIT AND VEGETABLES ... youtu.be/0uhWnFpgR6I?fe… via @YouTube @PrimaProgram @tesiscanalsur @OPI_uco
youtube.com
YouTube
🌱 DURINNPACK: LA REVOLUCIÓN DEL ENVASADO SOSTENIBLE QUE SALVA...
🗣️Alejandro Rodríguez (@arodpas), Catedrático de Ing.Quimica @Fac_CienciasUCO presenta uno de los grupos de investigación adscritos al @IQUEMA_ 👉🏻@BIOPREN_Group #RNM940 Ingeniería de los Productos y Bioprocesos
🗣️El pasado sábado, @agrosfera_tve emitió reportaje sobre el uso del alpeorujo para desarrollar baterías sostenibles. Esta investigación forma parte del proyecto Olive4Future, en el que el @IQUEMA (grupos RNM 271 y FQM 175) aporta su conocimiento a empresas como ACORA y COVIDESA
La @Univcordoba crea una alternativa al plástico: la nanocelulosa vegetal y bacteriana eldiadecordoba.es/cordoba/univer… vía @eldiacordoba
eldiadecordoba.es
La Universidad de Córdoba crea una alternativa al plástico: la nanocelulosa vegetal y bacteriana
El proyecto 'Boocell' de la UCO emplea residuos para desarrollar productos sostenibles
Actualidad Universitaria - El proyecto Boocell de la UCO emplea residuos para desarrollar productos sostenibles uco.es/servicios/actu…
En @tesiscanalsur se han interesado por el proyecto #DurInnPack, una innovación revolucionaria en el campo del envasado y la conservación de alimentos frescos. En él colabora personal investigador de Patología Agroforestal 👇
🌱 DurInnPack: un spray sostenible creado a partir de residuos orgánicos que alarga la vida de los alimentos frescos. 🍎✨ 📺 Hoy a las 21:00 h. en #AndalucíaTV @canalsur 👉 cedecom.es/noticias/durin… #DurInnPack @AgronomiaUCO @Fac_CienciasUCO @Univcordoba @CordobaCiencia @cedecom

Las week our scientific coordinator @AraGarNu presented @dur_pack project to the partners of Boocell project during the workshop meeting with collaborative companies. New synergies are coming! 📦🍅🍆👩🔬👨🌾 @PrimaProgram @Univcordoba



🔬Investigadores andaluces demuestran los beneficios de una comunidad bacteriana contra el cambio climático en el tomate 🍅 La herramienta protege a la planta contra el calor, tiene financiación de @UniversidadAnd y se pone a disposición del agricultor ➡️ lajunta.es/571c9

🗣️1st International Workshop WASTE VALORIZATION 8 November 2024 Venue: “Manuel Medina” Conference Hall, Government Building, Campus de Rabanales, @Univcordoba Free (limited to 40 places). Registration form: bit.ly/IQUEMAworkshop

United States Trends
- 1. #AEWDynamite N/A
- 2. Rockets N/A
- 3. Spurs N/A
- 4. Wemby N/A
- 5. Sengun N/A
- 6. Amen Thompson N/A
- 7. Andrade N/A
- 8. Ciampa N/A
- 9. Dylan Harper N/A
- 10. #TheMaskedSinger N/A
- 11. Jaylon Tyson N/A
- 12. #ChicagoPD N/A
- 13. Cavs N/A
- 14. Castle N/A
- 15. #PorVida N/A
- 16. Mikey N/A
- 17. Fulton County N/A
- 18. Nicki N/A
- 19. Cleveland N/A
- 20. #ChicagoFire N/A
Was dir gefallen könnte
-
 Carreño
Carreño
@04Fernandocc -
 Maria Paz Aguilar
Maria Paz Aguilar
@mpazuco2013 -
 JaviRojas10
JaviRojas10
@javirojas1043 -
 Fernando Solís
Fernando Solís
@fernandosoliss_ -
 tony De La Torre Garcia
tony De La Torre Garcia
@tonyDeLaTorreG1 -
 Nuria
Nuria
@Nuriajimebez02 -
 Cordobés
Cordobés
@Cordobes793 -
 Rafael
Rafael
@rafamh45 -
 JaimeZ
JaimeZ
@GZJ06 -
 Un Andaluz
Un Andaluz
@UnAndaluz1 -
 GolDePepillo 🤙🍦
GolDePepillo 🤙🍦
@GolDePepilloo -
 Luis Pérez
Luis Pérez
@luisperez63_ -
 Javier_ccf
Javier_ccf
@Javier29257984 -
 Vane Luque
Vane Luque
@vaneluqueleon
Something went wrong.
Something went wrong.





















































































































